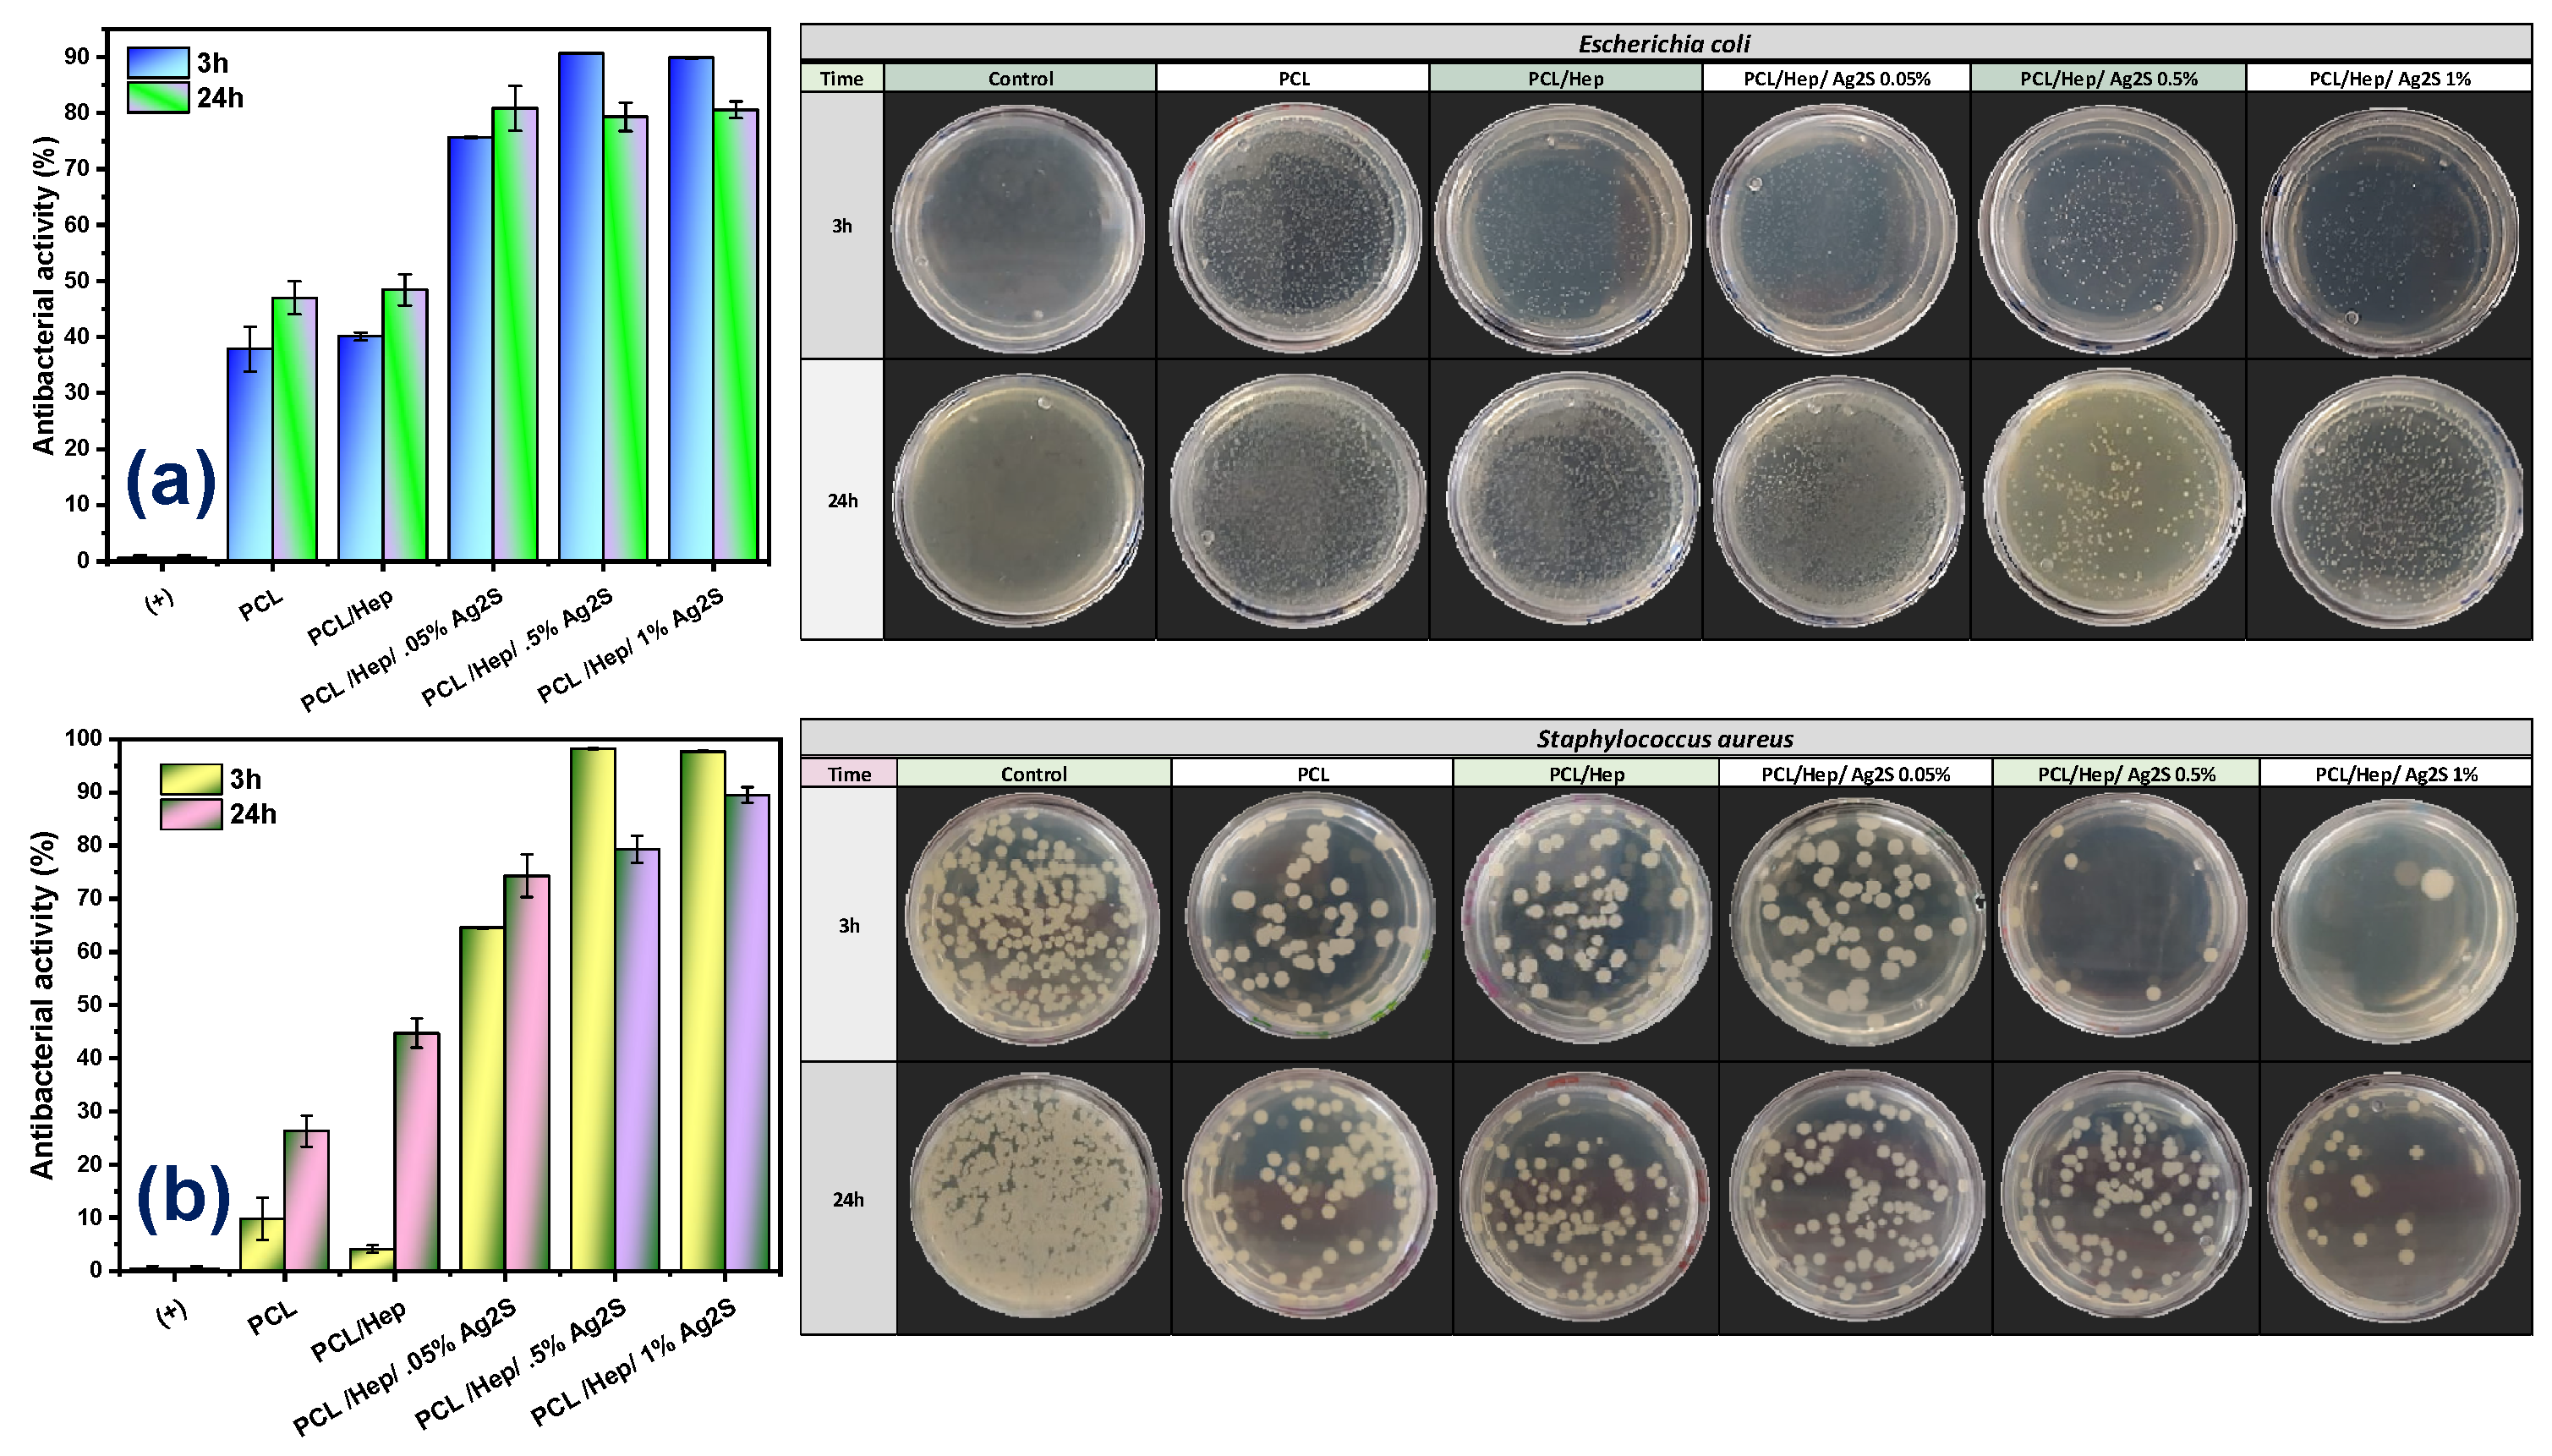

Multifunctional Biological Performance of Electrospun PCL Scaffolds Formulated with Silver Sulfide Nanoparticles
Abstract
1. Introduction
2. Materials and Methods
2.1. Green Synthesis of Ag2S Nanoparticles
2.2. Electrospun Scaffold Formulation of PCL/Ag2S Nanocomposites
2.3. Structural Characterization of Ag2S NPs and PCL/HEP/Ag2S Membranes
2.4. Antibacterial Activity
2.5. Biocompatibility Analysis of Electrospun PCL/Ag2S Nanocomposites
2.6. In Vivo Healing Response of Wounds with PCL/Ag2S Scaffolds
3. Results
3.1. Synthesis of Ag2S Nanoparticles
3.2. Morphology and Physicochemical Properties of Electrospun PCL/Ag2S Scaffolds
3.3. Antibacterial Performance of PCL/Ag2S Scaffolds
3.4. Controlled Ion Release of PCL/Ag2S Scaffolds by Cyclic Voltammetry
3.5. Biocompatibility Assays of PCL/Ag2S Scaffolds
3.6. In Vivo Tissue Regeneration Response of PCL/Ag2S Scaffolds in Wistar Rat Model
4. Conclusions
Supplementary Materials
Author Contributions
Funding
Institutional Review Board Statement
Data Availability Statement
Acknowledgments
Conflicts of Interest
References
- Echeverria Molina, M.I.; Molina, M.I.E.; Malollari, K.G.; Komvopoulos, K. Design Challenges in Polymeric Scaffolds for Tissue Engineering. Front. Bioeng. Biotechnol. 2021, 9, 617141. [Google Scholar] [CrossRef] [PubMed]
- Serrano-Aroca, Á.; Cano-Vicent, A.; i Serra, R.S.; El-Tanani, M.; Aljabali, A.; Tambuwala, M.M.; Mishra, Y.K. Scaffolds in the microbial resistant era: Fabrication, materials, properties and tissue engineering applications. Mater. Today Bio 2022, 16, 100412. [Google Scholar] [CrossRef] [PubMed]
- Bakhtiari, H.; Nouri, A.; Khakbiz, M.; Tolouei-Rad, M. Fatigue behaviour of load-bearing polymeric bone scaffolds: A review. Acta Biomater. 2023, 172, 16–37. [Google Scholar] [CrossRef]
- Hernández-Rangel, A.; Silva-Bermudez, P.; España-Sánchez, B.; Luna-Hernández, E.; Almaguer-Flores, A.; Ibarra, C.; Garcia-Perez, V.; Velasquillo, C.; Luna-Bárcenas, G. Fabrication and in vitro behavior of dual-function chitosan/silver nanocomposites for potential wound dressing applications. Mater. Sci. Eng. C Mater. Biol. Appl. 2018, 94, 750–765. [Google Scholar] [CrossRef]
- Luna-Hernández, E.; Cruz-Soto, M.; Padilla-Vaca, F.; Mauricio-Sánchez, R.; Ramirez-Wong, D.; Muñoz, R.; Granados-López, L.; Ovalle-Flores, L.; Menchaca-Arredondo, J.; Hernández-Rangel, A.; et al. Combined antibacterial/tissue regeneration response in thermal burns promoted by functional chitosan/silver nanocomposites. Int. J. Biol. Macromol. 2017, 105, 1241–1249. [Google Scholar] [CrossRef]
- Martins, A.; Araújo, J.V.; Reis, R.L.; Neves, N.M. Electrospun Nanostructured Scaffolds for Tissue Engineering Applications. Nanomedicine 2007, 2, 929–942. [Google Scholar] [CrossRef]
- Tonda-Turo, C.; Ruini, F.; Ceresa, C.; Gentile, P.; Varela, P.; Ferreira, A.M.; Fracchia, L.; Ciardelli, G. Nanostructured scaffold with biomimetic and antibacterial properties for wound healing produced by ‘green electrospinning’. Colloids Surf. B Biointerfaces 2018, 172, 233–243. [Google Scholar] [CrossRef]
- Anjum, S.; Rahman, F.; Pandey, P.; Arya, D.K.; Alam, M.; Rajinikanth, P.S.; Ao, Q. Electrospun Biomimetic Nanofibrous Scaffolds: A Promising Prospect for Bone Tissue Engineering and Regenerative Medicine. Int. J. Mol. Sci. 2022, 23, 9206. [Google Scholar] [CrossRef]
- Flores-Rojas, G.G.; Gómez-Lazaro, B.; López-Saucedo, F.; Vera-Graziano, R.; Bucio, E.; Mendizábal, E. Electrospun Scaffolds for Tissue Engineering: A Review. Macromol 2023, 3, 524–553. [Google Scholar] [CrossRef]
- Türkoğlu, G.C.; Khomarloo, N.; Mohsenzadeh, E.; Gospodinova, D.N.; Neznakomova, M.; Salaün, F. PVA-Based Electrospun Materials—A Promising Route to Designing Nanofiber Mats with Desired Morphological Shape—A Review. Int. J. Mol. Sci. 2024, 25, 1668. [Google Scholar] [CrossRef]
- Cui, C.; Sun, S.; Wu, S.; Chen, S.; Ma, J.; Zhou, F. Electrospun chitosan nanofibers for wound healing application. Eng. Regen. 2021, 2, 82–90. [Google Scholar] [CrossRef]
- Azari, A.; Golchin, A.; Maymand, M.M.; Mansouri, F.; Ardeshirylajimi, A. Electrospun Polycaprolactone Nanofibers: Current Research and Applications in Biomedical Application. Adv. Pharm. Bull. 2021, 12, 658–672. [Google Scholar] [CrossRef]
- Law, J.X.; Liau, L.L.; Saim, A.; Yang, Y.; Idrus, R. Electrospun Collagen Nanofibers and Their Applications in Skin Tissue Engineering. Tissue Eng. Regen. Med. 2017, 14, 699–718. [Google Scholar] [CrossRef]
- El-Seedi, H.R.; Said, N.S.; Yosri, N.; Hawash, H.B.; El-Sherif, D.M.; Abouzid, M.; Abdel-Daim, M.M.; Yaseen, M.; Omar, H.; Shou, Q.; et al. Gelatin nanofibers: Recent insights in synthesis, bio-medical applications and limitations. Heliyon 2023, 9, e16228. [Google Scholar] [CrossRef]
- Cortes, Y.Z.; Valenzuela, L.M.; Pena, E.A.E.; Sanchez, B.L.E. Antibacterial Activity of Electrospun Nanocomposites Fabricated by In Situ Chitosan/Silver Nanoparticles. IEEE Trans. NanoBioscience 2021, 21, 89–96. [Google Scholar] [CrossRef]
- Hernández-Orozco, M.M.; Castellanos-Espinoza, R.; Hernández-Santos, N.A.; Ramírez-Montiel, F.B.; Álvarez-Contreras, L.; Arellano-Arreola, V.M.; Padilla-Vaca, F.; Arjona, N.; España-Sánchez, B.L. Antibacterial and electrochemical evaluation of electrospun polyethersulfone/silver composites as highly persistent nanomaterials. Polym. Compos. 2022, 44, 1711–1724. [Google Scholar] [CrossRef]
- Pang, M.; Hu, J.; Zeng, H.C. Synthesis, Morphological Control, and Antibacterial Properties of Hollow/Solid Ag2S/Ag Heterodimers. J. Am. Chem. Soc. 2010, 132, 10771–10785. [Google Scholar] [CrossRef]
- Delgado-Beleño, Y.; Martinez-Nuñez, C.; Cortez-Valadez, M.; Flores-López, N.; Flores-Acosta, M. Optical properties of silver, silver sulfide and silver selenide nanoparticles and antibacterial applications. Mater. Res. Bull. 2018, 99, 385–392. [Google Scholar] [CrossRef]
- Awwad, A.M.; Salem, N.M.; Aqarbeh, M.M.; Abdulaziz, F.M. Green synthesis, characterization of silver sulfide nanoparticles and antibacterial activity evaluation. Chem. Int. 2019, 6, 42–48. [Google Scholar]
- Subramaniyan, S.B.; Megarajan, S.; Vijayakumar, S.; Mariappan, M.; Anbazhagan, V. Evaluation of the toxicities of silver and silver sulfide nanoparticles against Gram-positive and Gram-negative bacteria. IET Nanobiotechnol. 2019, 13, 326–331. [Google Scholar] [CrossRef]
- ASTM D3822/D3822M-14; Standard Test Method for Tensile Properties of Single Textile Fibers. ASTM International: West Conshohocken, PA, USA, 2020. [CrossRef]
- España-Sanchez, B.L.; Avila-Orta, C.A.; Padilla-Vaca, L.F.; Barriga-Castro, E.D.; Soriano-Corral, F.; Gonzalez-Morones, P.; Ramirez-Wong, D.G.; Luna-Barcenas, G. Early Stages of Antibacterial Damage of Metallic Nanoparticles by TEM and STEM-HAADF. Curr. Nanosci. 2017, 14, 54–61. [Google Scholar] [CrossRef]
- Salas, Z.H.; Ávila, A.F.M.; Orozco, M.M.H.; Peña, E.A.E.; Tirado, L.P.; Pérez, L.A.B.; Vaca, F.P.; Luna-Bárcenas, G.; Sánchez, B.L.E. Green synthesis of copper nanoparticles and their formulation into face masks: An antibacterial study. Polym. Compos. 2022, 44, 907–916. [Google Scholar] [CrossRef]
- Vanlalveni, C.; Lallianrawna, S.; Biswas, A.; Selvaraj, M.; Changmai, B.; Rokhum, S.L. Green synthesis of silver nanoparticles using plant extracts and their antimicrobial activities: A review of recent literature. RSC Adv. 2021, 11, 2804–2837. [Google Scholar] [CrossRef] [PubMed]
- Sadovnikov, S.I.; Kuznetsova, Y.V.; Rempel, A.A. Ag2S silver sulfide nanoparticles and colloidal solutions: Synthesis and properties. Nano-Struct. Nano-Objects 2016, 7, 81–91. [Google Scholar] [CrossRef]
- Sadovnikov, S.I.; Vovkotrub, E.G.; Rempel, A.A. Micro-Raman Spectroscopy of Nanostructured Silver Sulfide. Dokl. Phys. Chem. 2018, 480, 81–84. [Google Scholar] [CrossRef]
- Alekperov, O.; Jahangirli, Z.; Paucar, R. First-principles lattice dynamics and Raman scattering in ionic conductor β-Ag2S. Phys. Status Solidi (b) 2016, 253, 2049–2055. [Google Scholar] [CrossRef]
- Elsaeedy, H. A low temperature synthesis of Ag2S nanostructures and their structural, morphological, optical, dielectric and electrical studies: An effect of SDS surfactant concentration. Mater. Sci. Semicond. Process. 2019, 93, 360–365. [Google Scholar] [CrossRef]
- Fakhri, A.; Pourmand, M.; Khakpour, R.; Behrouz, S. Structural, optical, photoluminescence and antibacterial properties of copper-doped silver sulfide nanoparticles. J. Photochem. Photobiol. B Biol. 2015, 149, 78–83. [Google Scholar] [CrossRef]
- Can-Herrera, L.; Oliva, A.; Dzul-Cervantes, M.; Pacheco-Salazar, O.; Cervantes-Uc, J. Morphological and Mechanical Properties of Electrospun Polycaprolactone Scaffolds: Effect of Applied Voltage. Polymers 2021, 13, 662. [Google Scholar] [CrossRef]
- Luong-Van, E.; Grondahl, L.; Chua, K.N.; Leong, K.W.; Nurcombe, V.; Cool, S.M. Controlled release of heparin from poly(epsilon-caprolactone) electrospun fibers. Biomaterials 2006, 27, 2042–2050. [Google Scholar] [CrossRef]
- Leonés, A.; Mujica-Garcia, A.; Arrieta, M.P.; Salaris, V.; Lopez, D.; Kenny, J.M.; Peponi, L. Organic and Inorganic PCL-Based Electrospun Fibers. Polymers 2020, 12, 1325. [Google Scholar] [CrossRef] [PubMed]
- Ye, L.; Wu, X.; Mu, Q.; Chen, B.; Duan, Y.; Geng, X.; Gu, Y.; Zhang, A.; Zhang, J.; Feng, Z.-G. Heparin-Conjugated PCL Scaffolds Fabricated by Electrospinning and Loaded with Fibroblast Growth Factor 2. J. Biomater. Sci. Polym. Ed. 2011, 22, 389–406. [Google Scholar] [CrossRef]
- Górecka, Ż.; Idaszek, J.; Kołbuk, D.; Choińska, E.; Chlanda, A.; Święszkowski, W. The effect of diameter of fibre on formation of hydrogen bonds and mechanical properties of 3D-printed PCL. Mater. Sci. Eng. C 2020, 114, 111072. [Google Scholar] [CrossRef]
- Han, Y.; Xu, Y.; Zhang, S.; Li, T.; Ramakrishna, S.; Liu, Y. Progress of Improving Mechanical Strength of Electrospun Nanofibrous Membranes. Macromol. Mater. Eng. 2020, 305, 2000230. [Google Scholar] [CrossRef]
- Yaseri, R.; Fadaie, M.; Mirzaei, E.; Samadian, H.; Ebrahiminezhad, A. Surface modification of polycaprolactone nanofibers through hydrolysis and aminolysis: A comparative study on structural characteristics, mechanical properties, and cellular performance. Sci. Rep. 2023, 13, 9434. [Google Scholar] [CrossRef]
- Khunová, V.; Kováčová, M.; Olejniková, P.; Ondreáš, F.; Špitalský, Z.; Ghosal, K.; Berkeš, D. Antibacterial Electrospun Polycaprolactone Nanofibers Reinforced by Halloysite Nanotubes for Tissue Engineering. Polymers 2022, 14, 746. [Google Scholar] [CrossRef]
- Suresh, A.K.; Doktycz, M.J.; Wang, W.; Moon, J.W.; Gu, B.; Meyer, H.M.; Hensley, D.K.; Allison, D.P.; Phelps, T.J.; Pelletier, D.A. Monodispersed biocompatible silver sulfide nanoparticles: Facile extracellular biosynthesis using the γ-proteobacterium Shewanella oneidensis. Acta Biomater. 2011, 7, 4253–4258. [Google Scholar] [CrossRef]
- Cialdai, F.; Risaliti, C.; Monici, M. Role of fibroblasts in wound healing and tissue remodeling on Earth and in space. Front. Bioeng. Biotechnol. 2022, 10, 958381. [Google Scholar] [CrossRef]
- Farooq, M.; Khan, A.W.; Kim, M.S.; Choi, S. The Role of Fibroblast Growth Factor (FGF) Signaling in Tissue Repair and Regeneration. Cells 2021, 10, 3242. [Google Scholar] [CrossRef]
- Farahani, M.; Shafiee, A. Wound Healing: From Passive to Smart Dressings. Adv. Heal. Mater. 2021, 10, 2100477. [Google Scholar] [CrossRef]
- Ahmed, M.; Zayed, M.; El-Dek, S.; Hady, M.A.; El Sherbiny, D.H.; Uskoković, V. Nanofibrous ε-polycaprolactone scaffolds containing Ag-doped magnetite nanoparticles: Physicochemical characterization and biological testing for wound dressing applications in vitro and in vivo. Bioact. Mater. 2021, 6, 2070–2088. [Google Scholar] [CrossRef] [PubMed]
- Zivari-Ghader, T.; Hamishehkar, H.; Shokouhi, B.; Kosari-Nasab, M.; Farahpour, M.R.; Memar, M.Y.; Davaran, S.; Hanaee, J.; Rashidi, M.-R.; Mehrali, M. Chitosan-Alginate Hydrogel Enriched with Hypericum perforatum Callus Extract for Improved Wound Healing and Scar Inhibition. ACS Appl. Mater. Interfaces 2024, 16, 67344–67361. [Google Scholar] [CrossRef] [PubMed]
- Poshina, D.; Sokolova, N.; Nono-Tagne, S.; Ahmadi-Nohadani, H.; Gofman, I.; Mishanin, A.; Golovkin, A.; Skorik, Y.; Otsuka, I. Electrospinning of methacrylated alginate for tissue engineering applications. RSC Adv. 2024, 14, 38746–38756. [Google Scholar] [CrossRef] [PubMed]

Disclaimer/Publisher’s Note: The statements, opinions and data contained in all publications are solely those of the individual author(s) and contributor(s) and not of MDPI and/or the editor(s). MDPI and/or the editor(s) disclaim responsibility for any injury to people or property resulting from any ideas, methods, instructions or products referred to in the content. |
© 2025 by the authors. Licensee MDPI, Basel, Switzerland. This article is an open access article distributed under the terms and conditions of the Creative Commons Attribution (CC BY) license (https://creativecommons.org/licenses/by/4.0/).
Share and Cite
Torres-Pedroza, M.d.C.; Martínez-Ávila, A.F.; Juarez-Moreno, K.; Estevez, M.; Álvarez-Contreras, L.; Cruz-Soto, M.E.; Granados-López, L.; Arjona, N.; España-Sánchez, B.L. Multifunctional Biological Performance of Electrospun PCL Scaffolds Formulated with Silver Sulfide Nanoparticles. Polymers 2025, 17, 230. https://doi.org/10.3390/polym17020230
Torres-Pedroza MdC, Martínez-Ávila AF, Juarez-Moreno K, Estevez M, Álvarez-Contreras L, Cruz-Soto ME, Granados-López L, Arjona N, España-Sánchez BL. Multifunctional Biological Performance of Electrospun PCL Scaffolds Formulated with Silver Sulfide Nanoparticles. Polymers. 2025; 17(2):230. https://doi.org/10.3390/polym17020230
Chicago/Turabian StyleTorres-Pedroza, María del Carmen, Ariadna Fernanda Martínez-Ávila, Karla Juarez-Moreno, Miriam Estevez, Lorena Álvarez-Contreras, Martha Elena Cruz-Soto, Lucero Granados-López, Noé Arjona, and Beatriz Liliana España-Sánchez. 2025. "Multifunctional Biological Performance of Electrospun PCL Scaffolds Formulated with Silver Sulfide Nanoparticles" Polymers 17, no. 2: 230. https://doi.org/10.3390/polym17020230
APA StyleTorres-Pedroza, M. d. C., Martínez-Ávila, A. F., Juarez-Moreno, K., Estevez, M., Álvarez-Contreras, L., Cruz-Soto, M. E., Granados-López, L., Arjona, N., & España-Sánchez, B. L. (2025). Multifunctional Biological Performance of Electrospun PCL Scaffolds Formulated with Silver Sulfide Nanoparticles. Polymers, 17(2), 230. https://doi.org/10.3390/polym17020230

